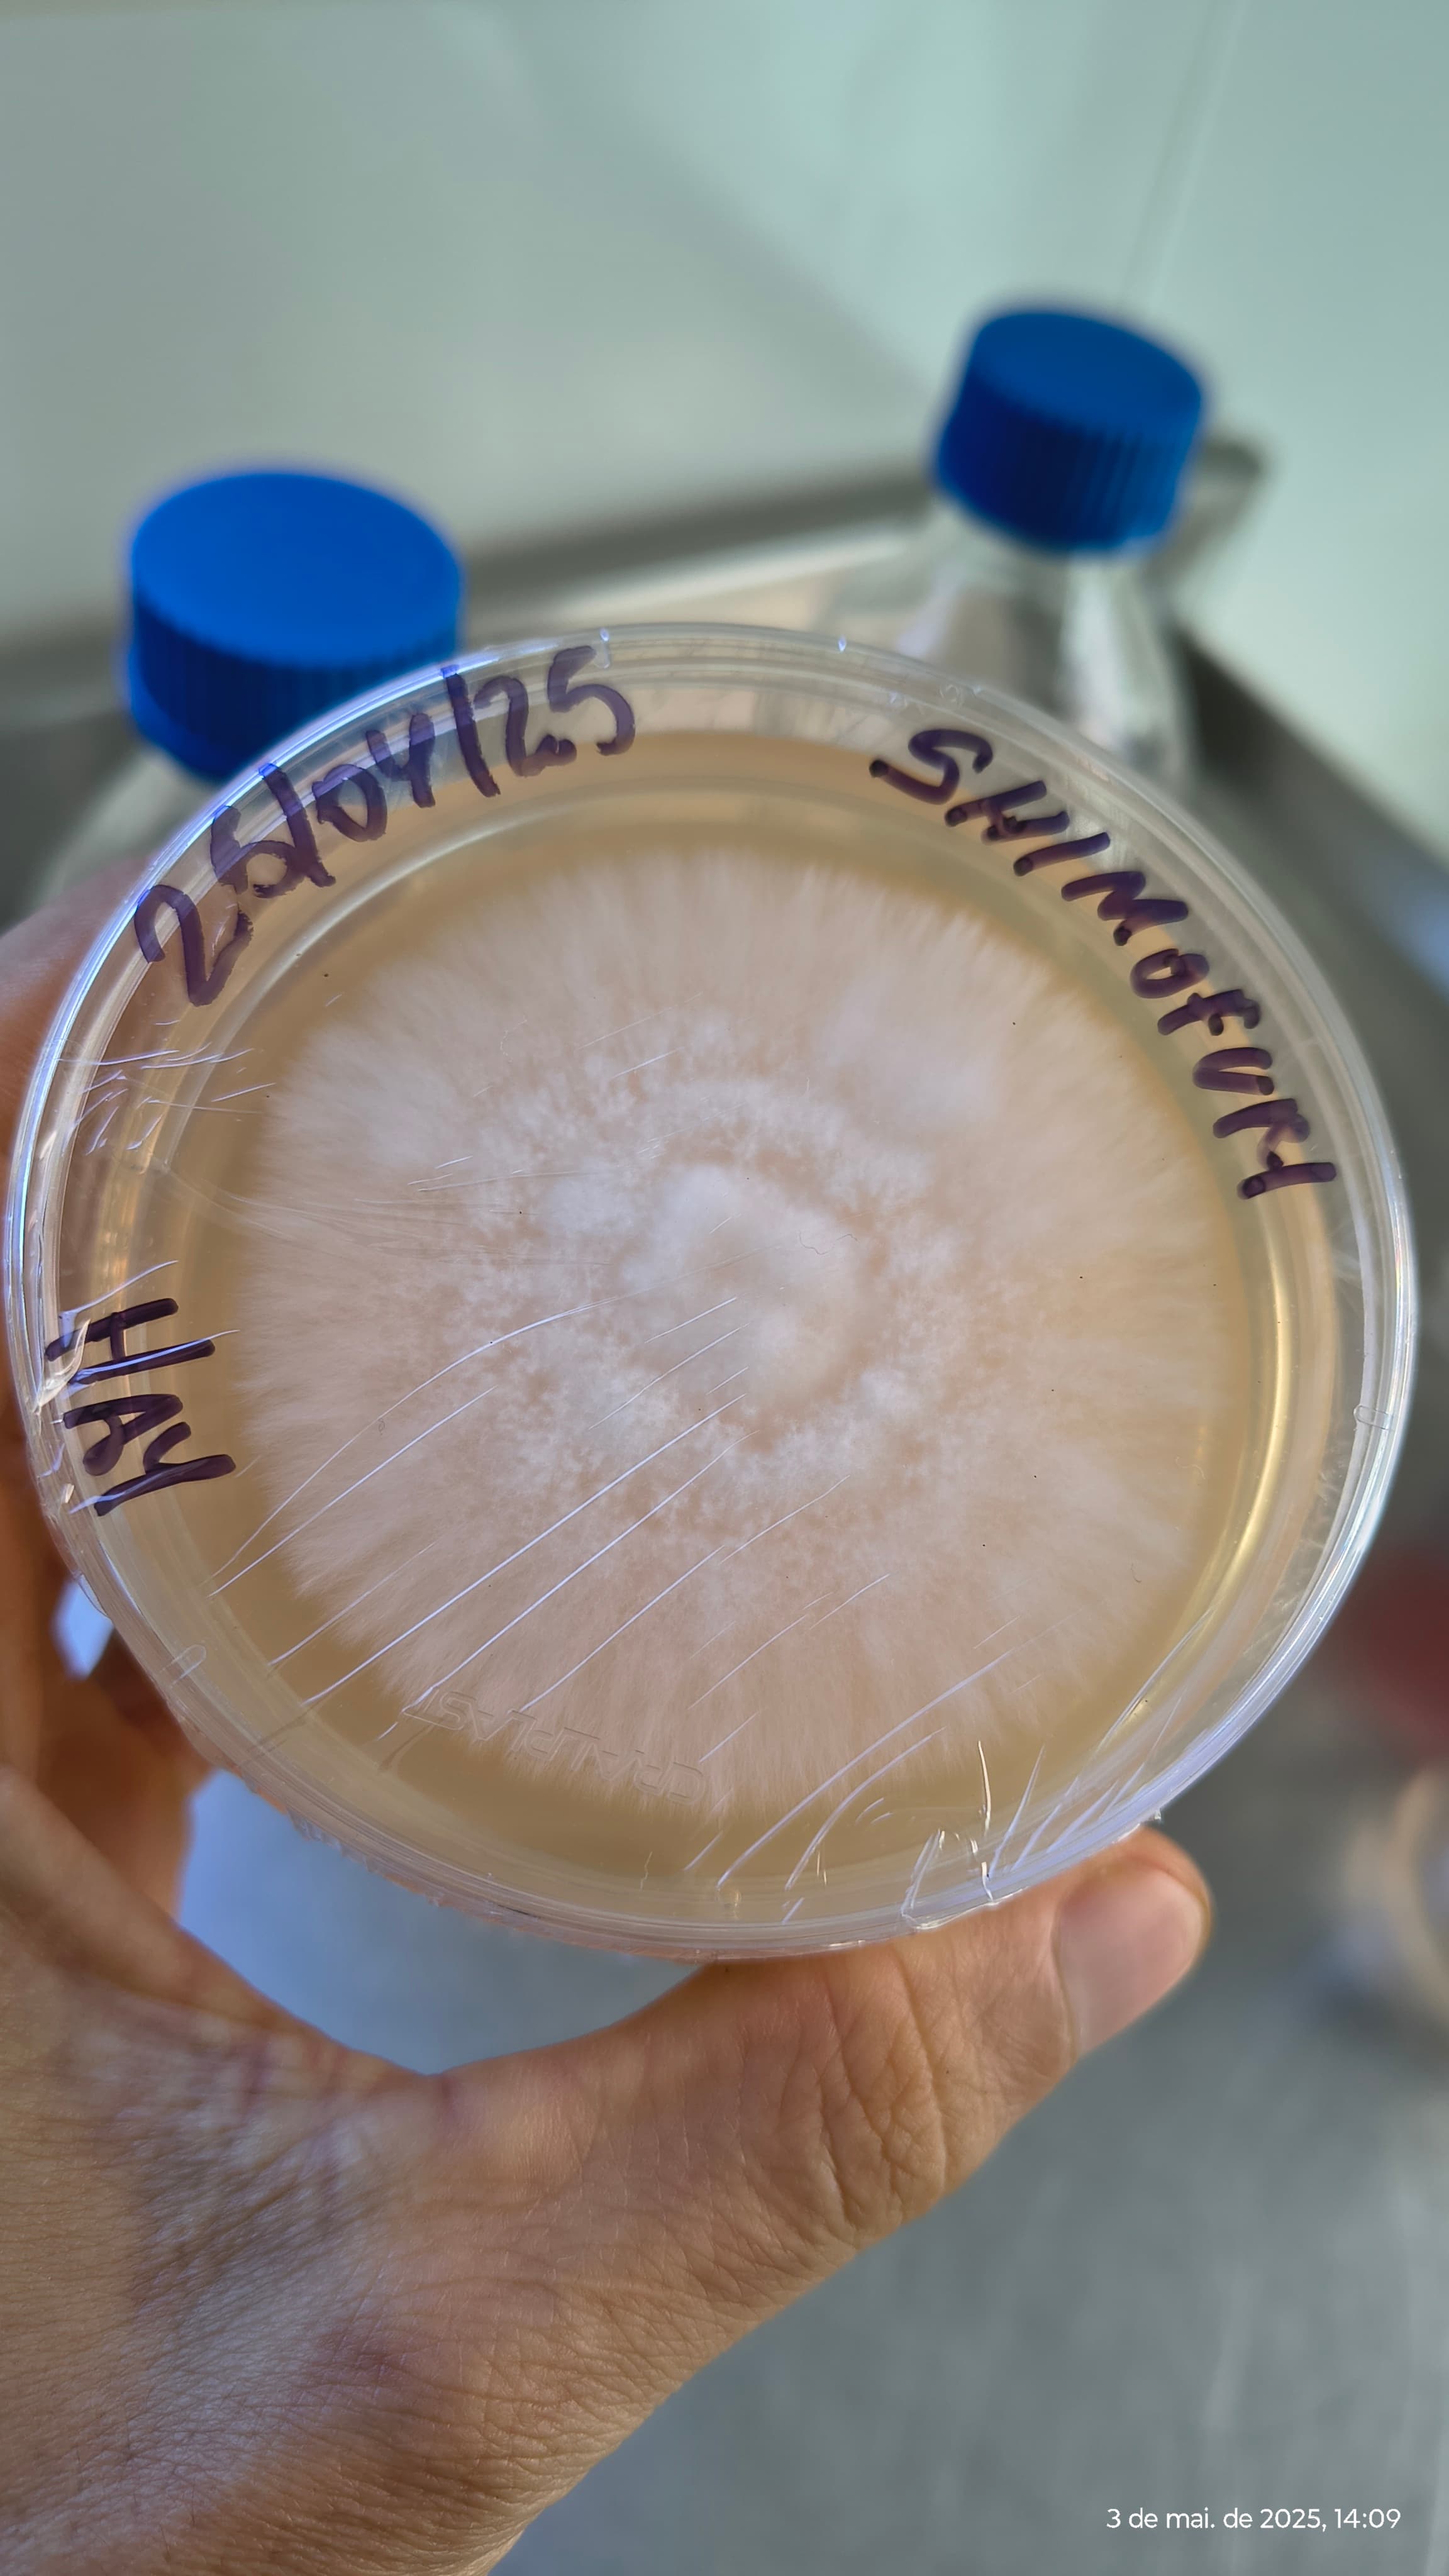
Clonagem e seleção de matrizes

Aprenda a cultivar cogumelos com quem vive isso na prática
A mentoria da Fungivale foi criada para quem quer começar do zero ou evoluir no cultivo com mais segurança, menos prejuízo e com orientação direta de quem realmente produz.
Uma metodologia simples, mas com atenção aos detalhes que fazem diferença, gerando mais eficiência, economia e consistência no processo.
Em 10 a 20 dias, você já pode começar a colher os primeiros resultados, dependendo da espécie.
Aplicável a mais de 12 espécies, entre cogumelos comestíveis e funcionais.

Não é uma mentoria baseada em teoria solta
A Fungivale nasceu da prática. Começamos com estrutura simples, erramos, ajustamos, aprendemos e evoluímos. Hoje unimos técnicas rústicas que funcionam com processos mais controlados e eficientes.
Experiência acumulada
Mais de uma década aprendendo no campo, no laboratório e na rotina real da produção.
Visão técnica e prática
Da genética ao spawn, do bloco ao ambiente de frutificação, com foco no que realmente funciona.
Atalho para evolução
Você economiza tempo, evita erros clássicos e ganha clareza para estruturar seu cultivo.
Para quem é a mentoria Fungivale
Se você se identifica com algum desses perfis, essa mentoria foi feita para você
Quem quer começar no cultivo e não sabe por onde iniciar
Quem já tentou sozinho e enfrentou contaminações ou travou no processo
Quem quer testar o próprio ambiente com blocos antes de investir mais
Quem quer aprender com mais direção, em vez de juntar conteúdo solto
Quem deseja produzir seus próprios cogumelos com mais consistência
Quem busca uma base mais séria para futuramente vender ou escalar
Galeria Fungivale
Um pouco da prática, da estrutura e da rotina real por trás da produção.

Clonagem e seleção de matrizes

Blocos de cultivo prontos para teste

Frutificação padronizada

Rotina prática de produção

Cogumelos funcionais

Adaptações acessíveis e eficientes

Ambiente rústico aproveitável

Climatização planejada

Laboratório otimizado

Venda programada

Colheitas diárias

Equipamentos econômicos
Fungivale na mídia
Participação da Fungivale na reportagem do programa Agro, Saúde e Cooperação.
Insumos e experiências práticas
Além da mentoria, você pode começar testando na prática com blocos, cultura líquida e spawn.
Blocos para cultivo
Ideal para quem quer viver a experiência em casa, testar o ambiente e entender a frutificação.
Cultura líquida
Material genético selecionado para quem deseja dar os próximos passos com mais controle.
Spawn em grãos
Spawn em trigo e aveia para quem busca colonização consistente e base mais profissional.
Mentoria Fungivale
O caminho mais direto para aprender com quem produz, evitar erros e acelerar sua evolução.
Mentoria Fungivale
Para quem quer parar de andar em círculos e aprender cultivo com direção, clareza e base prática.
O que você encontra na mentoria
Essa mentoria não é para curiosidade vazia
Ela é para quem realmente quer aprender, testar, ajustar e construir base sólida no cultivo.
Quer aprender com quem produz de verdade?
Me chama no WhatsApp para entender seu momento atual e verificar se a mentoria faz sentido para você.
Atendimento direto pelo WhatsApp
O que trava a maioria das pessoas
E por que orientação certa economiza tempo e dinheiro
Conteúdo demais, direção de menos
A pessoa consome muito conteúdo solto, mas não consegue transformar isso em processo.
Erro repetido no ambiente
Sem leitura correta do ambiente e do manejo, as perdas se repetem e desanimam.
Falta de visão do próximo passo
Mesmo quando começa, muita gente não sabe como evoluir do hobby para algo mais consistente.
Quem aprende com prática enxerga diferente
Depoimentos de nossos mentorados
“Tinha uma idéia de cultivo equivocada. Com a mentoria evitei perda de tempo e dinheiro. Gostei demais das idéias e da atenção individual.”
“Com pouco tempo para trabalhar todas as etapas do cultivo, resolvi comprar os blocos prontos e aprender apenas a etapa de frutificação. Foi um adianto enorme, pois mantive meu emprego enquanto entendia a demanda local, sem desperdícios.”
“Climatizei um quarto ocioso com isopor, plásticos e outros materiais acessíveis como exaustores de banheiro e ar condicionado. A mentoria foi fundamental para o layout efetivo. Consigo produzir o ano todo independente da estação do ano.”
Chega de tentar sozinho sem clareza
Se você quer aprender cultivo com mais direção, entender o que realmente importa e acelerar sua evolução, fale agora com a Fungivale.
Ao entrar em contato, você pode:
Atendimento direto • conversa prática • sem enrolação